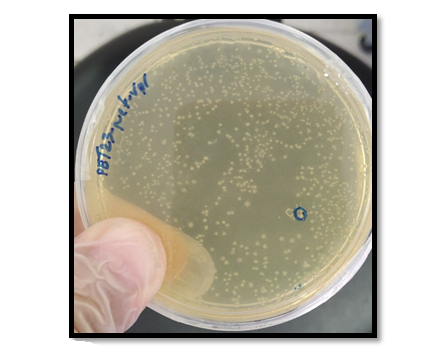

Volume 15, Issue 2 (Mar-Apr 2021)
mljgoums 2021, 15(2): 11-17 |
Back to browse issues page
Download citation:
BibTeX | RIS | EndNote | Medlars | ProCite | Reference Manager | RefWorks
Send citation to:



BibTeX | RIS | EndNote | Medlars | ProCite | Reference Manager | RefWorks
Send citation to:
Nikyar A, Bolhassani A, Rouhollah F, Heshmati M. Construction of a Prokaryotic Expression Vector harboring Two HIV-1 Accessory Genes. mljgoums 2021; 15 (2) :11-17
URL: http://mlj.goums.ac.ir/article-1-1356-en.html
URL: http://mlj.goums.ac.ir/article-1-1356-en.html
1- Department of Molecular and Cellular Sciences, Faculty of Advanced Sciences and Technology, Tehran Medical Sciences, Islamic Azad University, Tehran, Iran
2- Department of Hepatitis and AIDs, Pasteur Institute of Iran, Tehran, Iran ,A_bolhasani@pasteur.ac.ir
2- Department of Hepatitis and AIDs, Pasteur Institute of Iran, Tehran, Iran ,
Full-Text [PDF 856 kb]
(1852 Downloads)
| Abstract (HTML) (10816 Views)
Full-Text: (3150 Views)
INTRODUCTION
Acquired immune deficiency syndrome (AIDS) is a disease caused by infection with the human immunodeficiency virus (HIV) and still remains one of the leading causes of death worldwide. The virus belongs to the genus Lentivirus within the family of Retroviridae and can be transmitted through various body fluids or secretions, including blood, semen, milk, etc. (1). Since the start of the HIV epidemic, 75 million people have been infected with the virus, nearly 32 million of whom have died from the disease. According to the WHO, 38 million people were living with HIV in 2019 (2).
The HIV virus is classified into two types based on the characteristics and differences in viral antigens: HIV-1 and HIV-2. The virus genome consists of two RNA strands encapsulated in the envelope that encode nine viral genes (gag, pol, env, tat, rev, nef, vif, vpr, vpu). The genes gag, pol and env are involved in the production of structural proteins (matrix, capsid, nucleocapsid and p6), viral enzymes (protease, reverse transcriptase and integrase) and envelope proteins (Gp120 and Gp41). The remaining six genes encode regulatory proteins (Tat and Rev) and accessory proteins (Vif, Vpu / Vpx, Vpr, and Nef) (3).
Vpr is a relatively small protein containing 96 amino acids that is present in all HIV types (4). Despite its small size, the presence of this protein is essential for the optimal progression of the early stages of the virus life cycle in newly infected cells. The general functions of this protein include induction of cell cycle arrest (G2/M stage) and apoptosis, regulation of reverse transcription, insertion of viral DNA into macrophage nuclei and immune cells, facilitation of virus infection and regulation of transcription of viral and host genes (7, 8). Moreover, functional impairment in Vpr reduces the rate of disease progression in HIV patients (7). Nef is a 27-32 kDa protein, highly expressed in the early stages of the infection process that negatively affect the presence of CD4 and HLA molecules on the surface of HIV-infected cells, thereby slowing down the immune response, especially by CTL (8). This protein also promotes infectivity and pathogenesis, particularly in HIV-1. In addition to the various functions of this protein in infected cells, Nef can be released into the extracellular space in the form of virion or exosome and act as a good measure of viral protein expression in treated individuals (9).
Despite the benefits of antiviral drug combinations or highly active antiretroviral therapy, these drugs do not cure the disease and are associated with numerous side effects. This emphasizes the urgent need for developing novel or complementary therapies such as the development of new vaccines and antiviral drugs (10). The use of recombinant proteins allows the targeting of immune responses focused against particular antigens. In general, recombinant protein vaccines are safe, easy to produce in large quantities and free from potential concerns raised by traditional vaccines based on purified macromolecules (11). There are a variety of expression systems with different advantages, allowing the production of large quantities of proteins depending on the required characteristics. Multiple approaches utilizing viral and DNA vectors have shown promise in the development of an effective vaccine against HIV. The most straightforward method to produce large amounts of recombinant protein suitable for a vaccine is to clone the gene into a prokaryotic expression vector and produce the protein in Escherichia coli (12). Given the crucial role of HIV-1 accessory proteins Nef and Vpr in infectivity, viral proliferation and disease progression, we aimed to design a Nef-Vpr fusion construct and clone the construct into a prokaryotic vector to produce a potential immunogenic recombinant protein in future.
MATERIALS AND METHODS
PCR amplification of the Nef and Vpr accessory genes
Complete sequences of HIV-1 Nef and Vpr genes were obtained from the HIV-1 vector pNL4-3 available at the NCBI website (accession no. AF324493). Specific primers comprising the restriction site of relevant restriction enzymes were designed using the SnapGene software. Table 1 shows the sequence of the primers used for amplification of Nef and Vpr genes.
Table 1. Sequences of the primers used for amplification of HIV-1 Nef and Vpr genes
To obtain the genes, PCR amplification was performed using the pNL4-3 vector and pfu DNA polymerase. The final reaction solution (50 μl) contained 5 μl buffer (10X), 2 μl dNTP (2mM), 1 μl of each primer (10 pmol), 0.5 μl pfu DNA polymerase (2.5 U/μl), 1 μl pNL4.3 (100 ng) and 39 μl H2O. H2O was used as negative control. Cycling conditions were carried out as shown in Table 2. PCR products were subjected to agarose gel electrophoresis for 40 min at 90V.
Table 2. PCR program for amplification of Nef and Vpr genes
At first, the amplified Nef fragment was cloned into NheI and BamHI restriction sites of pET-23a (+) expression vector (Novagen, Merck, Germany). For this purpose, 10 μl of each template (the vector and gene) were digested in a final reaction solution of 50 μl containing 1.5 μl NheI (FastDigest, Thermo Scientific), 1.5 μl BamHI (FastDigest, Thermo Scientific), 5 μl buffer (10X) and 32 μl deionized water for one hour. The digested pET23a vector and Nef were first run on 0.8% agarose gel and then purified using the GEL/PCR Purification Mini Kit (FAVORGEN Biotech Co., Taiwan). The digested Nef gene was ligated into the linearized pET23a vector at the ratio of 1:7 (vector: gene) using T4 DNA ligase (Thermo Scientific, USA) and 10X T4 DNA ligase buffer for 16 hours at 4oC. Next, the ligation mixture was used to transform competent E. coli DH5α cells by heat shock. The pET23a vector harboring the Nef gene was extracted from recombinant clones using FavorPrep Plasmid DNA Extraction Mini Kit (FAVORGEN Biotech Co., Taiwan) and verified by restriction enzyme digestion.
PCR-amplified Vpr fragment was cloned into BamHI and HindIII restriction sites of the pET23a-Nef plasmid as explained for Nef. The digested Vpr and pET23a-Nef were first run on 0.8% agarose gel and then purified using the kit. Next, the ligation mixture was used to transform competent E. coli DH5α. Plasmid DNA containing pET23a-Nef-Vpr was extracted from recombinant clones using the kit. The concentration and purity of the pET23a-Nef-Vpr were evaluated using a NanoDrop spectrophotometer (Thermo Fisher Scientific, USA). Successful cloning of the Nef-Vpr construct into pET23a vector was verified by restriction enzyme digestion and sequencing. Bacteria stocks were prepared in 0.8% glycerol solution and stored at -70 oC for future use.
RESULTS
PCR amplification of the Nef and Vpr genes
Amplification of HIV-1 Nef and Vpr genes were carried out using specific primers. Detection of 620 bp and 291 bp fragments in agarose gel electrophoresis confirmed successful amplification of Nef and Vpr genes, respectively (Figure 1).
.PNG)
Figure 1. Detection of ~ 620 bp and ~ 291 bp fragments confirmed successful amplification of Nef and Vpr genes, respectively
The PCR-amplified Nef fragment was cloned into NheI and BamHI restriction sites of pET23a expression vector. Successful cloning of Nef gene was confirmed by enzymatic digestion of the plasmid with NheI and BamHI enzymes (Figure 2).

Figure 2. Detection of ~ 620 bp fragment after enzymatic digestion with NheI and BamHI enzymes confirmed cloning of Nef gene.
The amplified Vpr fragment was cloned into BamHI and HindIII restriction sites of the pET23a-Nef plasmid. The recombinant clones after transformation was shown in Figure 3. Successful cloning of the Nef-Vpr fusion was then confirmed by enzymatic digestion of the plasmid using NheI and HindIII enzymes (Figure 4).

Figure 3. Transformation of pET23-Nef-Vpr into the competent DH5α cells.

Figure 4. Successful cloning of Nef-Vpr fusion was confirmed by detection of ~911 bp band after enzymatic digestion of the pET23a-Nef-Vpr recombinant plasmid with NheI and HindIII enzymes. A. Undigested pET23a-Nef-Vpr (~ 4.5 kb); B. Digested plasmid (3.6 kb) and Nef-Vpr fragment (~911 bp).
DISCUSSION
HIV/AIDS remains a global health concern with over 39 million HIV/AIDS-related deaths to date. The recent advancements in antiviral drug combinations or highly active antiretroviral therapy and increased access to this therapy, have led to 51% reduction in HIV mortality and 17% reduction in incidence rates (13). However, the issue of finding complementary or alternative treatment and prevention strategies still persists.
Among numerous HIV genes examined for generation of immunogenic recombinant DNA and proteins, the highly-conserved HIV-1 accessory protein Nef has been widely regarded as a highly immunogenic candidate for development of therapeutic vaccines (14–17). This is mainly attributed to the main role of Nef in HIV pathogenesis via downregulation of cell-surface expression of multiple membrane-associated proteins, enhancement of virion infectivity, stimulation of viral replication, interference of cellular signal transduction, and manipulation of the apoptosis mechanism (14). On the other hand, Vpr has been known as a crucial component of HIV pathogenicity and progression. It is particularly involved in virus spread by promoting replication in dividing and non-dividing cells (18). It has been also suggested that targeting Vpr as an early-expressing HIV-1 protein could decrease HIV infection and CD4+-T-cell dysfunction (19). Both Nef and Vpr are highly-conserved HIV genes that have been long considered as promising targets for development of therapeutic strategies against HIV infection (20).
Despite its limitations, restriction digestion- and ligation-based cloning is still widely used to generate DNA constructs for a variety of molecular biology applications. Faster growth rate, higher plasmid yield and higher transformation efficiency are among the advantages of E. coli compared to other hosts, such as Saccharomyces cerevisiae (21). DH5α is one of the most popular E. coli strains used for maintenance and amplification of plasmid DNAs. These cells are suitable for stable production of recombinant plasmid DNA due to the recA and endA deletions, thereby preventing heterologous recombination to ensure a higher insert stability and endonuclease digestion of the plasmid during the isolation procedure (22).
Originally derived from pBR322, the pET system vectors controlled by the T7lac promoter, are a suitable choice for inducible heterologous expression of genes with high protein yields (23). According to Novagen, this series of vectors are the most robust vectors for cloning/ sub-cloning and overexpression of recombinant proteins in E. coli (24). There are various cloning strategies in order to generate protein expression constructs for structural and functional applications. In the present study, we used type II restriction endonucleases that cleave DNA outside of the recognition site, creating unique sticky ends that enable directional and seamless cloning of the gene of interest. Our PCR-amplified genes were inserted into the multiple cloning site of the pET23a vector, downstream of a T7 promoter for IPTG-inducible transcription by the T7 RNA polymerase. The pET vectors have been widely used for designing HIV proteins expression constructs (16,25–27). In the present study, we successfully constructed a recombinant fusion plasmid encoding a chimeric Nef-Vpr gene in pET23a expression vector for generation of a recombinant fusion protein in near future.
CONCLUSION
Generating recombinant vectors for efficient expression of HIV-1 antigens is a pivotal part of developing therapeutic and preventive vaccines. Given the higher effectiveness of multi-antigen HIV-1 targeted therapeutic strategies, in this study, we designed and constructed a recombinant prokaryotic vector harboring HIV-1 accessory genes Nef and Vpr. The expression of the recombinant Nef-Vpr fusion construct will be investigated in the next studies.
ACKNOWLEDGEMENTS
The authors would like to thank all those who helped us in this study.
CONFLICT OF INTEREST
The authors declare that there is no conflict of interest regarding publication of this study.
Acquired immune deficiency syndrome (AIDS) is a disease caused by infection with the human immunodeficiency virus (HIV) and still remains one of the leading causes of death worldwide. The virus belongs to the genus Lentivirus within the family of Retroviridae and can be transmitted through various body fluids or secretions, including blood, semen, milk, etc. (1). Since the start of the HIV epidemic, 75 million people have been infected with the virus, nearly 32 million of whom have died from the disease. According to the WHO, 38 million people were living with HIV in 2019 (2).
The HIV virus is classified into two types based on the characteristics and differences in viral antigens: HIV-1 and HIV-2. The virus genome consists of two RNA strands encapsulated in the envelope that encode nine viral genes (gag, pol, env, tat, rev, nef, vif, vpr, vpu). The genes gag, pol and env are involved in the production of structural proteins (matrix, capsid, nucleocapsid and p6), viral enzymes (protease, reverse transcriptase and integrase) and envelope proteins (Gp120 and Gp41). The remaining six genes encode regulatory proteins (Tat and Rev) and accessory proteins (Vif, Vpu / Vpx, Vpr, and Nef) (3).
Vpr is a relatively small protein containing 96 amino acids that is present in all HIV types (4). Despite its small size, the presence of this protein is essential for the optimal progression of the early stages of the virus life cycle in newly infected cells. The general functions of this protein include induction of cell cycle arrest (G2/M stage) and apoptosis, regulation of reverse transcription, insertion of viral DNA into macrophage nuclei and immune cells, facilitation of virus infection and regulation of transcription of viral and host genes (7, 8). Moreover, functional impairment in Vpr reduces the rate of disease progression in HIV patients (7). Nef is a 27-32 kDa protein, highly expressed in the early stages of the infection process that negatively affect the presence of CD4 and HLA molecules on the surface of HIV-infected cells, thereby slowing down the immune response, especially by CTL (8). This protein also promotes infectivity and pathogenesis, particularly in HIV-1. In addition to the various functions of this protein in infected cells, Nef can be released into the extracellular space in the form of virion or exosome and act as a good measure of viral protein expression in treated individuals (9).
Despite the benefits of antiviral drug combinations or highly active antiretroviral therapy, these drugs do not cure the disease and are associated with numerous side effects. This emphasizes the urgent need for developing novel or complementary therapies such as the development of new vaccines and antiviral drugs (10). The use of recombinant proteins allows the targeting of immune responses focused against particular antigens. In general, recombinant protein vaccines are safe, easy to produce in large quantities and free from potential concerns raised by traditional vaccines based on purified macromolecules (11). There are a variety of expression systems with different advantages, allowing the production of large quantities of proteins depending on the required characteristics. Multiple approaches utilizing viral and DNA vectors have shown promise in the development of an effective vaccine against HIV. The most straightforward method to produce large amounts of recombinant protein suitable for a vaccine is to clone the gene into a prokaryotic expression vector and produce the protein in Escherichia coli (12). Given the crucial role of HIV-1 accessory proteins Nef and Vpr in infectivity, viral proliferation and disease progression, we aimed to design a Nef-Vpr fusion construct and clone the construct into a prokaryotic vector to produce a potential immunogenic recombinant protein in future.
MATERIALS AND METHODS
PCR amplification of the Nef and Vpr accessory genes
Complete sequences of HIV-1 Nef and Vpr genes were obtained from the HIV-1 vector pNL4-3 available at the NCBI website (accession no. AF324493). Specific primers comprising the restriction site of relevant restriction enzymes were designed using the SnapGene software. Table 1 shows the sequence of the primers used for amplification of Nef and Vpr genes.
Table 1. Sequences of the primers used for amplification of HIV-1 Nef and Vpr genes
| Primer | Sequence 5`-3` |
| Forward-Nef | TAGCTAGCATGGGTGGCAAGTGGTC |
| Reverse-Nef | AGGGATCCGCAGTTCTTGAAGTAC |
| Forward-Vpr | AAGGATCCATGGAACAAGCCCCAG |
| Reverse-Vpr | AGAAGCTTGGATCTACTGGCTCC |
To obtain the genes, PCR amplification was performed using the pNL4-3 vector and pfu DNA polymerase. The final reaction solution (50 μl) contained 5 μl buffer (10X), 2 μl dNTP (2mM), 1 μl of each primer (10 pmol), 0.5 μl pfu DNA polymerase (2.5 U/μl), 1 μl pNL4.3 (100 ng) and 39 μl H2O. H2O was used as negative control. Cycling conditions were carried out as shown in Table 2. PCR products were subjected to agarose gel electrophoresis for 40 min at 90V.
Table 2. PCR program for amplification of Nef and Vpr genes
| Stage | Temperature | Time | Cycle(s) |
| Initial denaturation | 95 oC | 5 minutes | 1 |
| Denaturation | 95 oC | 30 seconds | 30 |
| Annealing | 63 oC | 45 seconds | |
| Extension | 72 oC | 60 seconds | |
| Final extension | 72 oC | 5 minutes | 1 |
At first, the amplified Nef fragment was cloned into NheI and BamHI restriction sites of pET-23a (+) expression vector (Novagen, Merck, Germany). For this purpose, 10 μl of each template (the vector and gene) were digested in a final reaction solution of 50 μl containing 1.5 μl NheI (FastDigest, Thermo Scientific), 1.5 μl BamHI (FastDigest, Thermo Scientific), 5 μl buffer (10X) and 32 μl deionized water for one hour. The digested pET23a vector and Nef were first run on 0.8% agarose gel and then purified using the GEL/PCR Purification Mini Kit (FAVORGEN Biotech Co., Taiwan). The digested Nef gene was ligated into the linearized pET23a vector at the ratio of 1:7 (vector: gene) using T4 DNA ligase (Thermo Scientific, USA) and 10X T4 DNA ligase buffer for 16 hours at 4oC. Next, the ligation mixture was used to transform competent E. coli DH5α cells by heat shock. The pET23a vector harboring the Nef gene was extracted from recombinant clones using FavorPrep Plasmid DNA Extraction Mini Kit (FAVORGEN Biotech Co., Taiwan) and verified by restriction enzyme digestion.
PCR-amplified Vpr fragment was cloned into BamHI and HindIII restriction sites of the pET23a-Nef plasmid as explained for Nef. The digested Vpr and pET23a-Nef were first run on 0.8% agarose gel and then purified using the kit. Next, the ligation mixture was used to transform competent E. coli DH5α. Plasmid DNA containing pET23a-Nef-Vpr was extracted from recombinant clones using the kit. The concentration and purity of the pET23a-Nef-Vpr were evaluated using a NanoDrop spectrophotometer (Thermo Fisher Scientific, USA). Successful cloning of the Nef-Vpr construct into pET23a vector was verified by restriction enzyme digestion and sequencing. Bacteria stocks were prepared in 0.8% glycerol solution and stored at -70 oC for future use.
RESULTS
PCR amplification of the Nef and Vpr genes
Amplification of HIV-1 Nef and Vpr genes were carried out using specific primers. Detection of 620 bp and 291 bp fragments in agarose gel electrophoresis confirmed successful amplification of Nef and Vpr genes, respectively (Figure 1).
.PNG)
Figure 1. Detection of ~ 620 bp and ~ 291 bp fragments confirmed successful amplification of Nef and Vpr genes, respectively
The PCR-amplified Nef fragment was cloned into NheI and BamHI restriction sites of pET23a expression vector. Successful cloning of Nef gene was confirmed by enzymatic digestion of the plasmid with NheI and BamHI enzymes (Figure 2).

Figure 2. Detection of ~ 620 bp fragment after enzymatic digestion with NheI and BamHI enzymes confirmed cloning of Nef gene.
The amplified Vpr fragment was cloned into BamHI and HindIII restriction sites of the pET23a-Nef plasmid. The recombinant clones after transformation was shown in Figure 3. Successful cloning of the Nef-Vpr fusion was then confirmed by enzymatic digestion of the plasmid using NheI and HindIII enzymes (Figure 4).
Figure 3. Transformation of pET23-Nef-Vpr into the competent DH5α cells.

Figure 4. Successful cloning of Nef-Vpr fusion was confirmed by detection of ~911 bp band after enzymatic digestion of the pET23a-Nef-Vpr recombinant plasmid with NheI and HindIII enzymes. A. Undigested pET23a-Nef-Vpr (~ 4.5 kb); B. Digested plasmid (3.6 kb) and Nef-Vpr fragment (~911 bp).
DISCUSSION
HIV/AIDS remains a global health concern with over 39 million HIV/AIDS-related deaths to date. The recent advancements in antiviral drug combinations or highly active antiretroviral therapy and increased access to this therapy, have led to 51% reduction in HIV mortality and 17% reduction in incidence rates (13). However, the issue of finding complementary or alternative treatment and prevention strategies still persists.
Among numerous HIV genes examined for generation of immunogenic recombinant DNA and proteins, the highly-conserved HIV-1 accessory protein Nef has been widely regarded as a highly immunogenic candidate for development of therapeutic vaccines (14–17). This is mainly attributed to the main role of Nef in HIV pathogenesis via downregulation of cell-surface expression of multiple membrane-associated proteins, enhancement of virion infectivity, stimulation of viral replication, interference of cellular signal transduction, and manipulation of the apoptosis mechanism (14). On the other hand, Vpr has been known as a crucial component of HIV pathogenicity and progression. It is particularly involved in virus spread by promoting replication in dividing and non-dividing cells (18). It has been also suggested that targeting Vpr as an early-expressing HIV-1 protein could decrease HIV infection and CD4+-T-cell dysfunction (19). Both Nef and Vpr are highly-conserved HIV genes that have been long considered as promising targets for development of therapeutic strategies against HIV infection (20).
Despite its limitations, restriction digestion- and ligation-based cloning is still widely used to generate DNA constructs for a variety of molecular biology applications. Faster growth rate, higher plasmid yield and higher transformation efficiency are among the advantages of E. coli compared to other hosts, such as Saccharomyces cerevisiae (21). DH5α is one of the most popular E. coli strains used for maintenance and amplification of plasmid DNAs. These cells are suitable for stable production of recombinant plasmid DNA due to the recA and endA deletions, thereby preventing heterologous recombination to ensure a higher insert stability and endonuclease digestion of the plasmid during the isolation procedure (22).
Originally derived from pBR322, the pET system vectors controlled by the T7lac promoter, are a suitable choice for inducible heterologous expression of genes with high protein yields (23). According to Novagen, this series of vectors are the most robust vectors for cloning/ sub-cloning and overexpression of recombinant proteins in E. coli (24). There are various cloning strategies in order to generate protein expression constructs for structural and functional applications. In the present study, we used type II restriction endonucleases that cleave DNA outside of the recognition site, creating unique sticky ends that enable directional and seamless cloning of the gene of interest. Our PCR-amplified genes were inserted into the multiple cloning site of the pET23a vector, downstream of a T7 promoter for IPTG-inducible transcription by the T7 RNA polymerase. The pET vectors have been widely used for designing HIV proteins expression constructs (16,25–27). In the present study, we successfully constructed a recombinant fusion plasmid encoding a chimeric Nef-Vpr gene in pET23a expression vector for generation of a recombinant fusion protein in near future.
CONCLUSION
Generating recombinant vectors for efficient expression of HIV-1 antigens is a pivotal part of developing therapeutic and preventive vaccines. Given the higher effectiveness of multi-antigen HIV-1 targeted therapeutic strategies, in this study, we designed and constructed a recombinant prokaryotic vector harboring HIV-1 accessory genes Nef and Vpr. The expression of the recombinant Nef-Vpr fusion construct will be investigated in the next studies.
ACKNOWLEDGEMENTS
The authors would like to thank all those who helped us in this study.
CONFLICT OF INTEREST
The authors declare that there is no conflict of interest regarding publication of this study.
Research Article: Original Paper |
Subject:
Molecular Medicine
Received: 2021/01/16 | Accepted: 2021/02/24 | Published: 2021/02/28 | ePublished: 2021/02/28
Received: 2021/01/16 | Accepted: 2021/02/24 | Published: 2021/02/28 | ePublished: 2021/02/28
References
1. German Advisory Committee Blood (Arbeitskreis Blut), Subgroup 'Assessment of Pathogens Transmissible by Blood' GACB (Arbeitskreis, Blood' S 'Assessment of PT by. Human Immunodeficiency Virus (HIV). Transfus Med Hemother. 2016; 43(3): 203-22. [DOI:10.1159/000445852] [PubMed]
2. Global HIV, Hepatitis and STIs Programme. [cited 2021 Jan 8]. Available from: https://www.who.int/teams/global-hiv-hepatitis-and-stis-programmes/data-use/hiv-data-and-statistics [View at Publisher]
3. Li G, De Clercq E. HIV Genome-Wide Protein Associations: a Review of 30 Years of Research. Microbiol Mol Biol Rev. 2016; 80(3): 679-731. [DOI:10.1128/MMBR.00065-15] [PubMed] [Google Scholar]
4. Tristem M, Purvis A, Quicke DLJ. Complex evolutionary history of primate lentiviral vpr genes. Virology. 1998 Jan 15;240(2):232-7. [DOI:10.1006/viro.1997.8929] [PubMed] [Google Scholar]
5. Guenzel CA, Hérate C, Benichou S. HIV-1 Vpr-a still "enigmatic multitasker. Front Microbiol. 2014; 5: 127. [View at Publisher] [DOI:10.3389/fmicb.2014.00127] [PubMed] [Google Scholar]
6. Lubow J, Collins KL. Vpr Is a VIP: HIV Vpr and Infected Macrophages Promote Viral Pathogenesis. Viruses. 2020; 12(8): 809. [View at Publisher] [DOI:10.3390/v12080809] [PubMed] [Google Scholar]
7. Zhao RY, Li G, Bukrinsky MI. Vpr-Host Interactions During HIV-1 Viral Life Cycle. J Neuroimmune Pharmacol. 2011; 6(2): 216-29. [DOI:10.1007/s11481-011-9261-z] [PubMed] [Google Scholar]
8. Basmaciogullari S, Pizzato M. The activity of Nef on HIV-1 infectivity. Front Microbiol. 2014; 5(MAY):232. [View at Publisher] [DOI:10.3389/fmicb.2014.00232] [PubMed] [Google Scholar]
9. Ferdin J, Goričar K, Dolžan V, Plemenitaš A, Martin JN, Peterlin BM, et al. Viral protein Nef is detected in plasma of half of HIV-infected adults with undetectable plasma HIV RNA. PLoS One. 2018; 13(1): e0191613. [DOI:10.1371/journal.pone.0191613] [PubMed] [Google Scholar]
10. Da-Yong-Lu, Wu H-Y, Yarla NS, Xu B, Ding J, Lu T-R. HAART in HIV / AIDS Treatments , a Current Limitation. EC Orthop. 2017; 4(Table 1): 140-6. [Google Scholar]
11. Nascimento IP, Leite LCC. Recombinant vaccines and the development of new vaccine strategies [Internet]. Vol. 45, Brazilian Journal of Medical and Biological Research. Associação Brasileira de Divulgação Científica; 2012 [cited 2021 Jan 2]. p. 1102-11. Available from: /pmc/articles/PMC3854212/?report=abstract [DOI:10.1590/S0100-879X2012007500142] [PubMed] [Google Scholar]
12. Daemi A, Hosseinzadeh S, Rafati S, Zahedifard F, Rajabi Bazl M, Doustdari F, et al. HPV16 E7-CT (gp96) fusion protein: Molecular cloning, expression and purification of a recombinant 6xHis-tagged protein in E. coli. J Paramed Sci. 2012; 3(2): 2-7. [View at Publisher] [Google Scholar]
13. Pandey A, Galvani AP. The global burden of HIV and prospects for controlLancet HIV. 2019; 6(12): e809-e811. [DOI:10.1016/S2352-3018(19)30230-9] [PubMed] [Google Scholar]
14. Wen J, Hao W, Fan Y, Du J, Du B, Qian M, et al. Co-delivery of LIGHT expression plasmid enhances humoral and cellular immune responses to HIV-1 Nef in mice. Arch Virol. 2014; 159(7): 1663-9. [View at Publisher] [DOI:10.1007/s00705-014-1981-y] [PubMed] [Google Scholar]
15. Tähtinen M, Strengell M, Collings A, Pitkänen J, Kjerrström A, Hakkarainen K, et al. DNA vaccination in mice using HIV-1 nef, rev and tat genes in self-replicating pBN-vector. Vaccine. 2001; 19(15-16): 2039-47. [View at Publisher] [DOI:10.1016/S0264-410X(00)00420-5] [PubMed] [Google Scholar]
16. Jafarzade BS, Bolhassani A, Sadat SM, Yaghobi R. Delivery of HIV-1 Nef Protein in Mammalian Cells Using Cell Penetrating Peptides as a Candidate Therapeutic Vaccine. Int J Pept Res Ther. 2017; 23(1): 145-53. [View at Publisher] [DOI:10.1007/s10989-016-9547-3] [Google Scholar]
17. Xie XY, Wan YM, Li B, Shi JJ, Qiu C, Liu ZQ, et al. Immunogenicity of DNA vaccines encoding regulatory/accessory proteins derived from three different prevalent strains in China. Chinese J Microbiol Immunol. 2011; 31(2): 157-61. [Google Scholar]
18. Gonzalez ME. The HIV-1 vpr protein: A multifaceted target for therapeutic intervention. International Journal of Molecular Sciences. MDPI AG. 2017; 73(5): 4101-9. [DOI:10.3390/ijms18010126] [PubMed] [Google Scholar]
19. Hrimech M, Yao X-J, Bachand F, Rougeau N, Cohen ÉA. Human Immunodeficiency Virus Type 1 (HIV-1) Vpr Functions as an Immediate-Early Protein during HIV-1 Infection. J Virol [Internet]. 1999; 73(5): 4101-9. [DOI:10.1128/JVI.73.5.4101-4109.1999] [PubMed] [Google Scholar]
20. Miller RH, Sarver N. HIV accessory proteins as therapeutic targets. Nat Med. 1997; 3(4): 389-94. [DOI:10.1038/nm0497-389] [PubMed] [Google Scholar]
21. Kostylev M, Otwell AE, Richardson RE, Suzuki Y. Cloning should be simple: Escherichia coli DH5á-mediated assembly of multiple DNA fragments with short end homologies. PLoS One. 2015; 10(9): e0137466. [DOI:10.1371/journal.pone.0137466] [PubMed] [Google Scholar]
22. Phue JN, Sang JL, Trinh L, Shiloach J. Modified Escherichia coli B (BL21), a superior producer of plasmid DNA compared with Escherichia coli K (DH5α). Biotechnol Bioeng. 2008; 101(4): 831-6. [DOI:10.1002/bit.21973] [PubMed] [Google Scholar]
23. Dobrijevic D, Nematollahi LA, Hailes HC, Ward JM. pET expression vector customized for efficient seamless cloning. Biotechniques. 2020; 69(5): 384-7. [View at Publisher] [DOI:10.2144/btn-2020-0101] [PubMed] [Google Scholar]
24. Gay G, Wagner DT, Keatinge-Clay AT, Gay DC. Rapid modification of the pET-28 expression vector for ligation independent cloning using homologous recombination in Saccharomyces cerevisiae. Plasmid. 2014; 76: 66-71. [View at Publisher] [DOI:10.1016/j.plasmid.2014.09.005] [PubMed] [Google Scholar]
25. Davoodi S, Bolhassani A, Sadat SM, Irani S. Enhancing HIV-1 Nef Penetration into Mammalian Cells as an Antigen Candidate. J Med Microbiol Infect Dis. 2019; 7(1): 37-43. [View at Publisher] [DOI:10.29252/JoMMID.7.1.2.37] [PubMed] [Google Scholar]
26. Davoodi S, Bolhassani A, Sadat SM, Irani S. Design and in vitro delivery of HIV-1 multi-epitope DNA and peptide constructs using novel cell-penetrating peptides. Biotechnol Lett. 2019; 41(11): 1283-98. [View at Publisher] [DOI:10.1007/s10529-019-02734-x] [PubMed] [Google Scholar]
27. Elbahnasawy MA, Farag MMS, Mansour MT, El-Ghamery AA. Cloning, expression and nanodiscs assemble of recombinant HIV-1 gp41. Microb Pathog. 2020;138. [DOI:10.1016/j.micpath.2019.103824] [PubMed] [Google Scholar]
Send email to the article author
| Rights and permissions | |
 |
This work is licensed under a Creative Commons Attribution-NonCommercial 4.0 International License. |









 goums.ac.ir
goums.ac.ir yahoo.com
yahoo.com